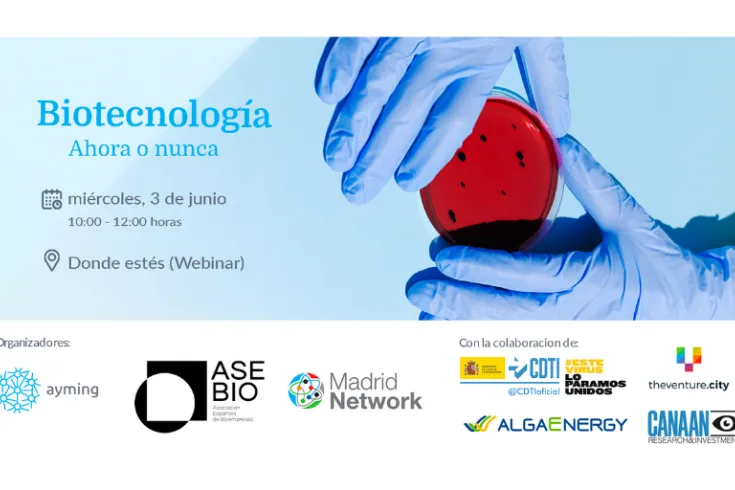
Webinar: "Biotecnología: ahora o nunca"

Buscar
Sumario de resultados
TIpos de contenido
Fecha
-
 Evento
EventoColaboración con startups en la era post COVID-19
¿Cómo puede la situación actual en la que estamos inmersos a nivel global con COVID-19 afectar la colaboración entre corporates y startups, y cómo estas colaboraciones pu
-
 Convocatoria
Convocatoria7ª Llamada Multisectorial España - India (DST-GITA)
-
 Nota de prensa
Nota de prensaAsebio Investor Day, el punto de encuentro de la inversión especializada en biotecnología
Asebio reúne a 60 inversores interesados en proyectos ‘biotech’ españoles de 9 países. Más de 500 oportunidades para las empresas participantes en reuniones de ‘partnering’
-
 Oferta de empleo
Oferta de empleoBCN HEALTH busca Consultor en Regulatory Affairs
-
 Evento
EventoJornada de presentación de las Consultas Preliminares al Mercado de los proyectos de Compr...
La Consulta Preliminar al Mercado de los proyectos busca ideas y soluciones innovadoras por parte de operadores económicos y otros agentes del conocimiento que permitan r
-
Evento
EventoWebinar: "Biotecnología: ahora o nunca"
La Biotecnología ha sido la gran olvidada, pero ahora tiene la clave para cambiar el mundo
-
 Noticia
NoticiaSpringer Nature presenta un área dedicada a empresas y entidades que se especializan en bi...
Los investigadores necesitan un acceso continuo a la investigación farmacológica global con el fin de ofrecer iniciativas de investigación comerciales sólidas para adelantarse a la competencia y
-
 Nota de prensa
Nota de prensaUna alianza para acelerar el diseño de nuevas terapias contra el cáncer
Chemotargets, con sede en el Parc Científic de Barcelona, ha firmado un acuerdo estratégico con el Instituto Hospital del Mar de Investigaciones Médicas
-
 Evento
EventoInnovación: la respuesta a los retos del COVID-19
El objetivo del evento es promover el debate sobre la innovación y fomentar la visibilidad de España como país puntero en investigación y desarrollo
-
 Noticia
NoticiaDos estrategias de la Comisión Europea se refuerzan en pro de un futuro sostenible y compe...
La Comisión Europea adopta una nueva Estrategia sobre la biodiversidad para devolver la naturaleza a nuestras vidas y una Estrategia "de la granja a la mesa" en pro de un sistema alimentario
-
 Empresa
EmpresaTECNIC BIOPROCESS SOLUTIONS
-
 Noticia
NoticiaNueva plataforma desarrollada para conectar las industrias de base biológica y las regione...
Plataforma que el Consorcio de Industrias de base biológica (BIC) en asociación con el Comité de Regiones de Europa (CDR) desarrollaron para conectar las industrias de base biológica y las regiones
-
 Noticia
NoticiaLos 5 sentidos de la entrevista virtual
Artículo de opinión escrito por Juan Diego Casas, Director de la Práctica Healthcare de Talengo
-
 Oferta de empleo
Oferta de empleoBioinformático nivel Intermedio o Senior
-
 Evento
EventoWebinar: Segunda convocatoria extraordinaria para expresiones de interés relacionadas con ...
La Comisión Europea organiza el evento informativo para los interesados en la convocatoria extraordinaria para expresiones de interés relacionadas con la COVID-
-
 Convocatoria
ConvocatoriaAbierta segunda convocatoria extraordinaria COVID-19
-
-
 Noticia
NoticiaProyectos de Compra Pública de Innovación Equilin-061, PIBICRA y Car-T
Desde AseBio os invitamos a participar en 3 proyectos de Compra Pública de Innovación del Servicio Andaluz de Salud, de casi 9 millones de euros
-
 Nota de prensa
Nota de prensaMinoryx dosifica el primer paciente pediátrico con leriglitazona para tratar la cALD
El estudio podría servir para registrar el fármaco en la Agencia Europea del Medicamento
-
 Nota de prensa
Nota de prensaDroplite abre una ronda de 600.000€ para acelerar la fabricación de su dispositivo intelig...
Desarrollo industrial de un dispositivo inteligente para el diagnóstico médico en tiempo real en el punto de atención al paciente (Point of Care, POC)
-
 Nota de prensa
Nota de prensaADmit Therapeutics obtiene el respaldo de la Alzheimer’s Drug Discovery Foundation
Una inversión de la 497.652 de dólares para desarrollar su test de diagnóstico precoz de la enfermedad de Alzheimer en muestras de sangre
